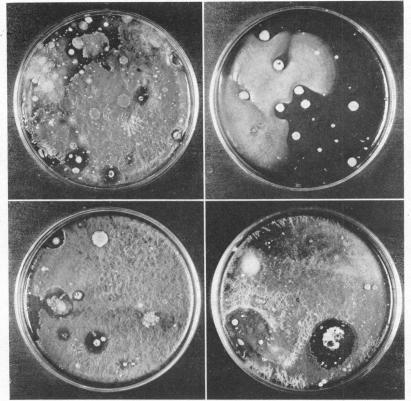

The Isolation from Soil of Spore-Forming Bacteria Which Produce Bactericidal Substances.
作者信息
Stokes J L, Woodward C R
机构信息
Research Laboratory, Merck and Co., Inc., Rahway, N. J.
出版信息
J Bacteriol. 1942 Feb;43(2):253-63. doi: 10.1128/jb.43.2.253-263.1942.
Abstract
摘要